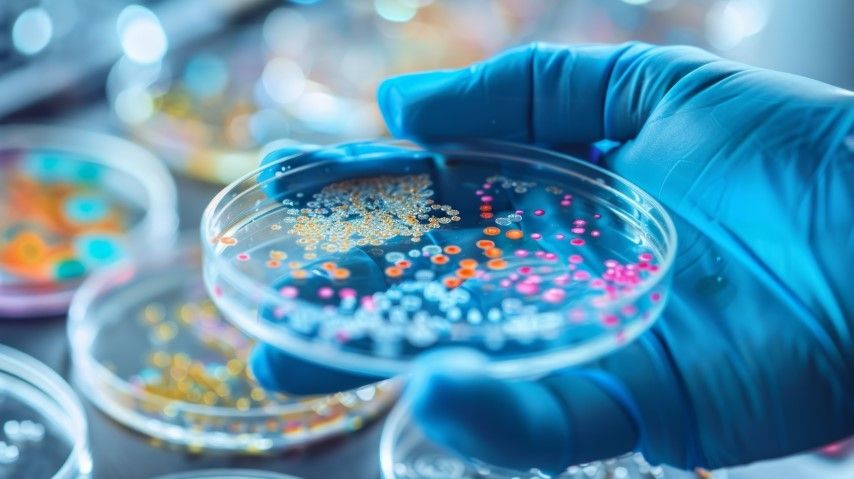

Kunde werden
Anmelden
Bakterienbefall in wassermischbaren Kühlschmierstoffen (KSS) ist in der Metallbearbeitung ein bekanntes Problem. Häufig wird die Anwendung von Bioziden empfohlen, um die Bakterienbelastung zu kontrollieren. Ist die Belastung jedoch zu hoch, bleibt oft nur ein Austausch des KSS. Der Einsatz von Bioziden birgt jedoch erhebliche Risiken für die Gesundheit der Mitarbeiter. Daher hat sich Jokisch bewusst gegen diese Praxis entschieden.
Um Bakterienbefall effektiv vorzubeugen, ist es wichtig, die Entstehungsmechanismen zu verstehen. Kühlschmierstoffe enthalten Nährstoffe, Sauerstoff, Mineralien und Wasser – alles, was Bakterien zum Überleben brauchen. Hohe Temperaturen, wie sie im Sommer oder bei anspruchsvollen Bearbeitungen auftreten, fördern zusätzlich die Vermehrung. Die modernen Kühlschmierstoffe von Jokisch sind mit konservierenden Stoffen ausgestattet, die unter normalen Bedingungen einen stabilen Schutz bieten, sofern die Sollkonzentration eingehalten und der pH-, Nitrit- sowie Nitratwert regelmäßig kontrolliert werden.
Mikroorganismen wie Bakterien gelangen meist unbeabsichtigt in den KSS – etwa über die Umgebungsluft, Anmischwasser, Werkstücke oder durch den Arbeitsprozess selbst. Auch „bewusste“ Kontaminationen durch Lebensmittelreste, Zigarettenkippen oder andere organische Stoffe sind häufige Ursachen. Verunreinigungen durch Bodenschmutz oder Korrosionsschutzmittel vom Werkstück tragen ebenfalls zur Belastung bei.
Mikroorganismen nutzen die Bestandteile des KSS als Nahrungsquelle, vermehren sich und hinterlassen Stoffwechselprodukte, die den KSS destabilisieren können. Schwefelhaltige Moleküle können zu unangenehm riechendem Schwefelwasserstoff führen, während aus Stickstoffverbindungen Nitrit entsteht – ein Indikator für Bakterienwachstum (gemäß TRGS 611). Bakterien bilden oft resistente Biofilme, die Leitungen verstopfen und das System langfristig beeinträchtigen. Zudem können einige Bakterien Endotoxine freisetzen, die Atembeschwerden bei den Mitarbeitern verursachen können.
Die richtige Pflege des KSS ist entscheidend, um Mikroorganismen in Schach zu halten.
Wichtig ist, die Einträge von Mikroorganismen zu minimieren und die empfohlene Konzentration des KSS einzuhalten. Große Volumenschwankungen sollten vermieden und durch regelmäßiges Nachfüllen ausgeglichen werden. Eine wöchentliche Kontrolle und Dokumentation von pH-Wert, Nitrit, Nitrat und Konzentration sind essenziell, um frühzeitig Maßnahmen ergreifen zu können.
Mit der Einführung der TRGS 611 haben sich die Vorschriften zur Kontrolle wassermischbarer KSS verschärft. Grenzwertüberschreitungen, etwa bei Nitritwerten über 20 ppm, erhöhen das Risiko der Bildung gesundheitsschädlicher Nitrosamine. Eine Verdünnung oder der Austausch des KSS sind in solchen Fällen unerlässlich.
Bei Überschreiten der Grenzwerte von 20 ppm für Nitrit besteht die Gefahr der Nitrosaminbildung, die eine gesundheitliche Gefährdung darstellen kann. In solchen Fällen sollte der Kühlschmierstoff ausgewechselt oder mit frischem Kühlschmierstoff verdünnt werden. Eine regelmäßige Nitrosaminmessung ist daher empfehlenswert, um mögliche Risiken frühzeitig zu erkennen.
Der pH-Wert des Kühlschmierstoffs sollte bei einer 5%igen Konzentration idealerweise bei etwa 9 liegen. Ein starker Abfall des pH-Wertes kann auf eine zu niedrige Konzentration oder beginnenden Bakterienbefall hinweisen. Abhilfe kann hier die Zugabe von Sauerstoff durch Umwälzen der Emulsion in Kombination mit einer Erhöhung der Konzentration schaffen. Um die Emulsion „atmen“ zu lassen, sollten Fremdöle regelmäßig von der Tankoberfläche entfernt werden, zum Beispiel mit einem geeigneten Skimmer wie dem Jokisch Fosia Skim B.M.

Die Jokisch GmbH bietet ein breites Sortiment an nitritfreien, wassermischbaren Kühlschmierstoffen, die „frei von sekundären Aminen“ sind. Unsere Kühlschmierstoffe kombinieren optimale Arbeitssicherheit mit hoher Leistung. Die konservierenden Stoffe bieten unter den richtigen Bedingungen stabilen Schutz vor Verkeimung und unterstützen die Gesundheit der Mitarbeiter. Unsere Außendienstmitarbeiter stehen Ihnen für eine fachkundige Beratung zur Seite, um das passende Produkt für Ihre Anwendung zu finden.
Nur mit Wasser nachfüllen: Selbst, wenn die Emulsionskonzentration zu hoch ist, sollte der Tank nicht mit reinem Wasser aufgefüllt werden. Eine Emulsion in geringer Konzentration beizumischen, reduziert das Risiko einer Unausgewogenheit des Kühlschmierstoffs.

Jeder moderne Kühlschmierstoff benötigt regelmäßige Wartung und Pflege. Eine kontinuierliche Überwachung und professionelle Betreuung sind entscheidend, um eine stabile Leistung und Biostabilität zu gewährleisten.
Bitte beachten Sie stets die Vorgaben aus dem technischen Merkblatt sowie den Sicherheitsdatenblättern. Diese stehen Ihnen zum Download beim jeweiligen Produkt zur Verfügung. Unser Produkt sollte sich zu ca. 5-10 % in Ihrer Maschine befinden. Eine ausreichend hohe Einsatzkonzentration ist essenziell, um die Biostabilität sicherzustellen. Ein entscheidender Faktor ist die Einhaltung der vorgegebenen Einsatzkonzentration. Daher empfehlen wir dringend eine wöchentliche Überprüfung – diese ist gesetzlich vorgeschrieben.
Beachten Sie zudem stets die Anforderungen der TRGS 611 für den sachgemäßen Umgang mit KSS.
Wir unterstützen Sie gerne bei der optimalen Pflege und Überwachung Ihrer Kühlschmierstoffe. Sprechen Sie uns an – gemeinsam finden wir die optimale Lösung für Ihre Anforderungen.
Die bereitgestellten Informationen wurden mit größter Sorgfalt erstellt und basieren auf unserem aktuellen Wissen und Erfahrungen. Dennoch übernehmen wir keine Gewähr für Vollständigkeit, Richtigkeit oder Anwendbarkeit im Einzelfall. Zerspanung ist oft sehr individuell und ist nicht immer auf andere Bearbeitungen zu übertragen. Deshalb bieten wir Ihnen gerne eine individuelle Beratung durch unsere Fachberater an, insbesondere bei sicherheitsrelevanten oder gesetzlich geregelten Anwendungen.
Stand: 25.04.2025